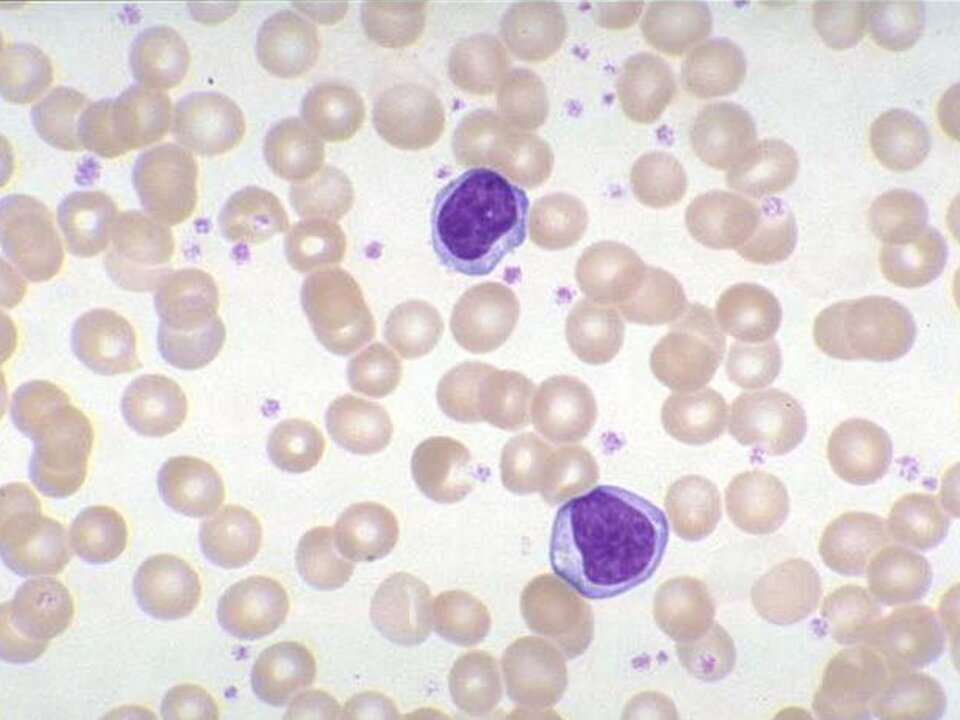
Na fotografii z mikroskopu świetlnego w powiększeniu tysiąckrotnym znajdują się limfocyty w formie fioletowych punktów, które nie mają ziarnistości w cytozolu, a ich jądra komórkowe są zaokrąglone lub mają nerkowaty kształt.

Układ krążenia
Skład i funkcje krwi
Omówisz rolę erytrocytów, i trombocytów oraz składników osocza.
Przedstawisz rolę krwi w transporcie gazów oddechowych.
Funkcje krwi
W ciele zwierząt krążą różne płyny. Pełnią one określone funkcje, np. odżywcze, transportowe czy odpornościowe. Jednym z nich jest krew, która zapewnia łączność między poszczególnymi częściami ciała. Najważniejsze funkcje krwi przedstawia poniższa ilustracja interaktywna.
Skład krwi
Krew jest tkanką łączną składającą się z płynnego osocza (substancja międzykomórkowa) oraz zawieszonych w nim elementów morfotycznych (komórek krwi).
Osocze - płynna część krwi
Osocze stanowi ok. **55%**objętości krwi. To żółtawy płyn zawierający ok. 90% wody. Resztę stanowią białka m.in. przeciwciała oraz substancje odżywcze (glukoza, aminokwasy, witaminy, wolne kwasy tłuszczowe) oraz zbędne produkty przemiany materii (mocznik, kwas moczowy, kreatyninę). Ponadto w osoczu występują hormony i liczne enzymy, które biorą udział w procesach przemiany materii. Blisko 1% składu osocza stanowią jony sodu, chloru, potasu, wapnia, magnezu i żelaza. W osoczu są również rozpuszczone gazy: tlen, dwutlenek węgla i azot.
Elementy morfotyczne krwi
Elementy morfotyczne stanowią ok. 45% objętości krwi. Zalicza się do nich: erytrocyty(krwinki czerwone), leukocyty(krwinki białe) oraz trombocyty(płytki krwi). Do leukocytów zalicza się: neutrofile, eozynofile, bazofile, limfocytyi monocyty.
Poszczególne elementy morfotyczne krwi pełnią wyspecjalizowane funkcje.
Elementy morfotyczne | Liczba w mul (mmIndeks górny 33) | |
|---|---|---|
Erytrocyty | 4,5–5,5 mln | |
Leukocyty | 5–8 tys. | |
Trombocyty | 200–300 tys. | |
Elementy morfotyczne | % leukocytów | |
|---|---|---|
Granulocyty | ||
Neutrofile (granulocyty obojętnochłonne) | 55–65% | |
Eozynofile (granulocyty kwasochłonne) | 2–4% | |
Bazofile (granulocyty zasadochłonne) | 0,5–1% | |
Agranulocyty | ||
Limfocyty | 25–35% | |
Monocyty | 4–8% | |
Indeks dolny Na podstawie: Encyklopedia biologiczna, pod red. Zdzisława Otłęgi, Wydawnictwo OPRES, Kraków 1998. Indeks dolny koniecNa podstawie: Encyklopedia biologiczna, pod red. Zdzisława Otłęgi, Wydawnictwo OPRES, Kraków 1998.
Układ krwiotwórczy człowieka odpowiada za produkcję komórek krwi. Wszystkie elementy morfotyczne powstają z komórek pochodzących od jednej embrionalnej, niezróżnicowanej komórki macierzystej. Elementy krwi powstają przede wszystkim w czerwonym szpiku kostnymczerwonym szpiku kostnym.
Aktywność tego układu zależy od wielu czynników i zmienia się wraz ze zmianą stanu organizmu, np. w przypadku niedotlenienia szpik kostny produkuje więcej erytrocytów, a w infekcjach tworzy więcej leukocytów. Z kolei w niektórych stanach patologicznych (po napromieniowaniu, po przyjmowaniu niektórych toksycznych leków) szpik kostny zanika, przez co zostaje osłabiona produkcja wszystkich tych komórek.
Dla zainteresowanych
Grupy krwi
U ludzi występują 4 główne grupy krwi: A, B, AB, 0. O rodzaju każdej z nich decyduje obecność na powierzchni błon erytrocytów specjalnych białek – antygenów. Osoba z grupą krwi A posiada erytrocyty z antygenami A. Krwinki grupy B na powierzchni erytrocytów mają antygeny B, a krwinki grupy AB – oba rodzaje antygenów (A i B). Erytrocyty pozbawione antygenów warunkują grupę 0.
Dodatkowo w osoczu krwi występują 2 rodzaje białek – przeciwciał: anty‑A oraz anty‑B. Powodują one zlepianie się, czyli aglutynacjęaglutynację krwinek: przeciwciała anty‑A zlepiają erytrocyty posiadające antygen A, przeciwciała anty‑B zlepiają erytrocyty posiadajace antygen B. Osocze krwi grupy 0 zawiera oba rodzaje przeciwciał, a w osoczu krwi grupy AB nie ma ich w ogóle.

W białkach błonowych erytrocytów człowieka występuje grupa około ośmiu antygenów nazywanych czynnikiem Rh. Wśród nich najbardziej immunogennym, czyli najłatwiej wywołującym pojawianie się przeciwciał skierowanych przeciw niemu, jest antygen D. Jest on obecny u blisko 84% Europejczyków.

W układzie grupowym Rh nie ma naturalnych przeciwciał skierowanych przeciwko antygenowi D. Jednak jeśli osobie o grupie Rh- zostanie podana krew grupy Rh+, to jej układ odpornościowy rozpocznie wytwarzanie przeciwciał anty‑D.

Film dostępny pod adresem /preview/resource/R1ZC863EFZJ15
Animacja przedstawia oznaczanie grup krwi.
Transfuzja krwi
Krew to życiodajny płyn podawany chorym, którzy stracili go w wyniku wypadku lub operacji. Przetoczenia krwi – transfuzji potrzebują czasem również osoby mające za małą ilość erytrocytów, spowodowaną na przykład anemią. Warunkiem bezpiecznej transfuzji jest zgodność grupy krwi biorcy i dawcy.

Podsumowanie
Krew składa się z osocza i elementów morfotycznych.
Osocze to płynna część krwi (ok. 55%), w większości woda z rozpuszczonymi białkami, solami mineralnymi, hormonami, składnikami odżywczymi i produktami przemiany materii,
Elementy morfotyczne:
- erytrocyty (krwinki czerwone) – zawierają hemoglobinę i transportują tlen oraz częściowo dwutlenek węgla;
- leukocyty (krwinki białe) – uczestniczą w obronie organizmu przed drobnoustrojami i w reakcjach odpornościowych, dzieli się je na agranulocyty (monocyty i limfocyty) oraz granulocyty (neutrofile, bazofile, eozynofile);
- trombocyty (płytki krwi) – biorą udział w procesie krzepnięcia.Funkcje krwi:
- transportowa – przenosi gazy oddechowe, składniki odżywcze, produkty przemiany materii i hormony,
- regulacyjna – pomaga utrzymywać stałą temperaturę i pH organizmu,
- obronna – uczestniczy w reakcjach odpornościowych i zwalczaniu drobnoustrojów,
- hemostatyczna – dzięki płytkom krwi i czynnikom krzepnięcia zapobiega utracie krwi.Komórki krwi powstają w czerwonym szpiku kostnym, grasicy i śledzionie.
Grupy krwi wynikają z obecności określonych antygenów na powierzchni erytrocytów oraz odpowiednich przeciwciał w osoczu; w układzie AB0 wyróżnia się grupy A, B, AB i 0, a dodatkowym czynnikiem różnicującym jest obecność (Rh+) lub brak (Rh–) antygenu D.
Ćwiczenia utrwalające
Wróć do polecenia na stronie „Na dobry początek” i dopisz brakujące definicje. Pamiętaj, żeby nie kopiować słownika, ale wyjaśnić każde słowo kluczowe w miarę możliwości swoimi słowami.